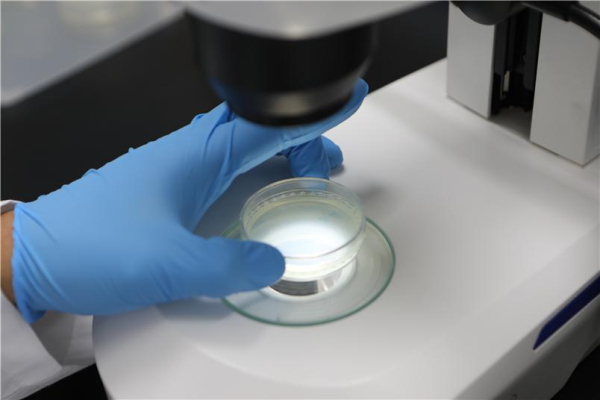
예쁜꼬마선충 현미경 관찰 모습

[충청뉴스 이성현 기자] 안전성평가연구소(KIT)가 인하대와 미국 텍사스 사우스웨스턴 의과대 연구팀과 교감신경 전달신호가 휴면난모세포를 유지하는 주요한 인자임을 확인했다고 28일 밝혔다.
일반적으로 난모세포는 다세포동물의 암컷이 가지는 생식세포로 난자를 생성하는 세포다. 여성은 태어나기 전에 이미 휴면난모세포 풀을 형성하며, 이는 사춘기 및 폐경의 시점을 결정하는 것으로 알려져 있다.
난모세포는 난소에 휴면상태로 존재하며 원칙적으로 증식하지 않기 때문에 생식능력을 오래 유지하기 위해 필수적으로 휴면상태를 유지하게 된다. 하지만 휴면난모세포가 비정상적으로 분화하는 경우 불임과 조기폐경 등을 유발하는 주요한 원인으로 추측되고 있다.
연구팀은 이번 연구를 통해 교감신경에서 분비되는 무척추동물의 옥토파민과 척추동물의 노르에피네트린이 휴면난모세포의 유지에 필수적인 물질임을 확인하고, 교감신경 전달신호가 영양분의 상태에 따라 휴면난모세포의 보존상태를 조절하는 것으로 확인했다.
이를 위해 연구팀은 무척추동물로 예쁜꼬마선충, 초파리, 척추동물로 제브라피쉬를 동물모델로 활용했다.
옥토파민이 결핍된 돌연변이 초파리에서 휴면난모세포 상태를 관찰했을 때, 휴면난모세포를 축적하지 못한 것을 확인했다. 반면 영양분을 섭취하지 못했음에도 정상 암컷 초파리가 휴면난모세포를 축적하는 것을 확인했다.
특히 해당 돌연변이체에 외부에서 옥토파민을 공급하게 되면 다시 정상적으로 휴면난모세포를 축적할 수 있다는 것을 확인함으로서 옥토파민이 무척추동물의 휴면난모세포 유지에 필수적이라는 것을 알 수 있다.
척추동물 모델 제브라피쉬가 교감신경물질인 노르에피네프린에 결핍된 경우, 영양분이 제한되면 휴면난모세포를 유지하지 못함을 동일하게 확인함으로서 교감신경물질과 영양분이 휴면난모세포를 유지했다.
또 불임의 원인의 하나로 알려진 다낭성 난소 증후군과 교감신경의 상관관계는 임상적으로 입증돼 있으나, 정확한 기전은 알려져있지 않았으며 비만 및 과영양상태가 다낭성 난소증후군을 초래한다는 연구 결과도 많이 나오고 있으나 그 기전 또한 확인되지 않았다.
연구팀은 연구를 통해 과영양상태로 인해 몸의 영양분 인지가 과다하게 증가하면, 이에 균형을 맞춰줄 교감신경이 점차 고갈되어 결국 다낭성 난소 증후군을 유발할 수도 있다는 가능성을 제시했다.
한편, 이번 연구는 국제학술지 네이처의 자매지 ‘Nature Communications’에 지난 11월 게재됐다.


